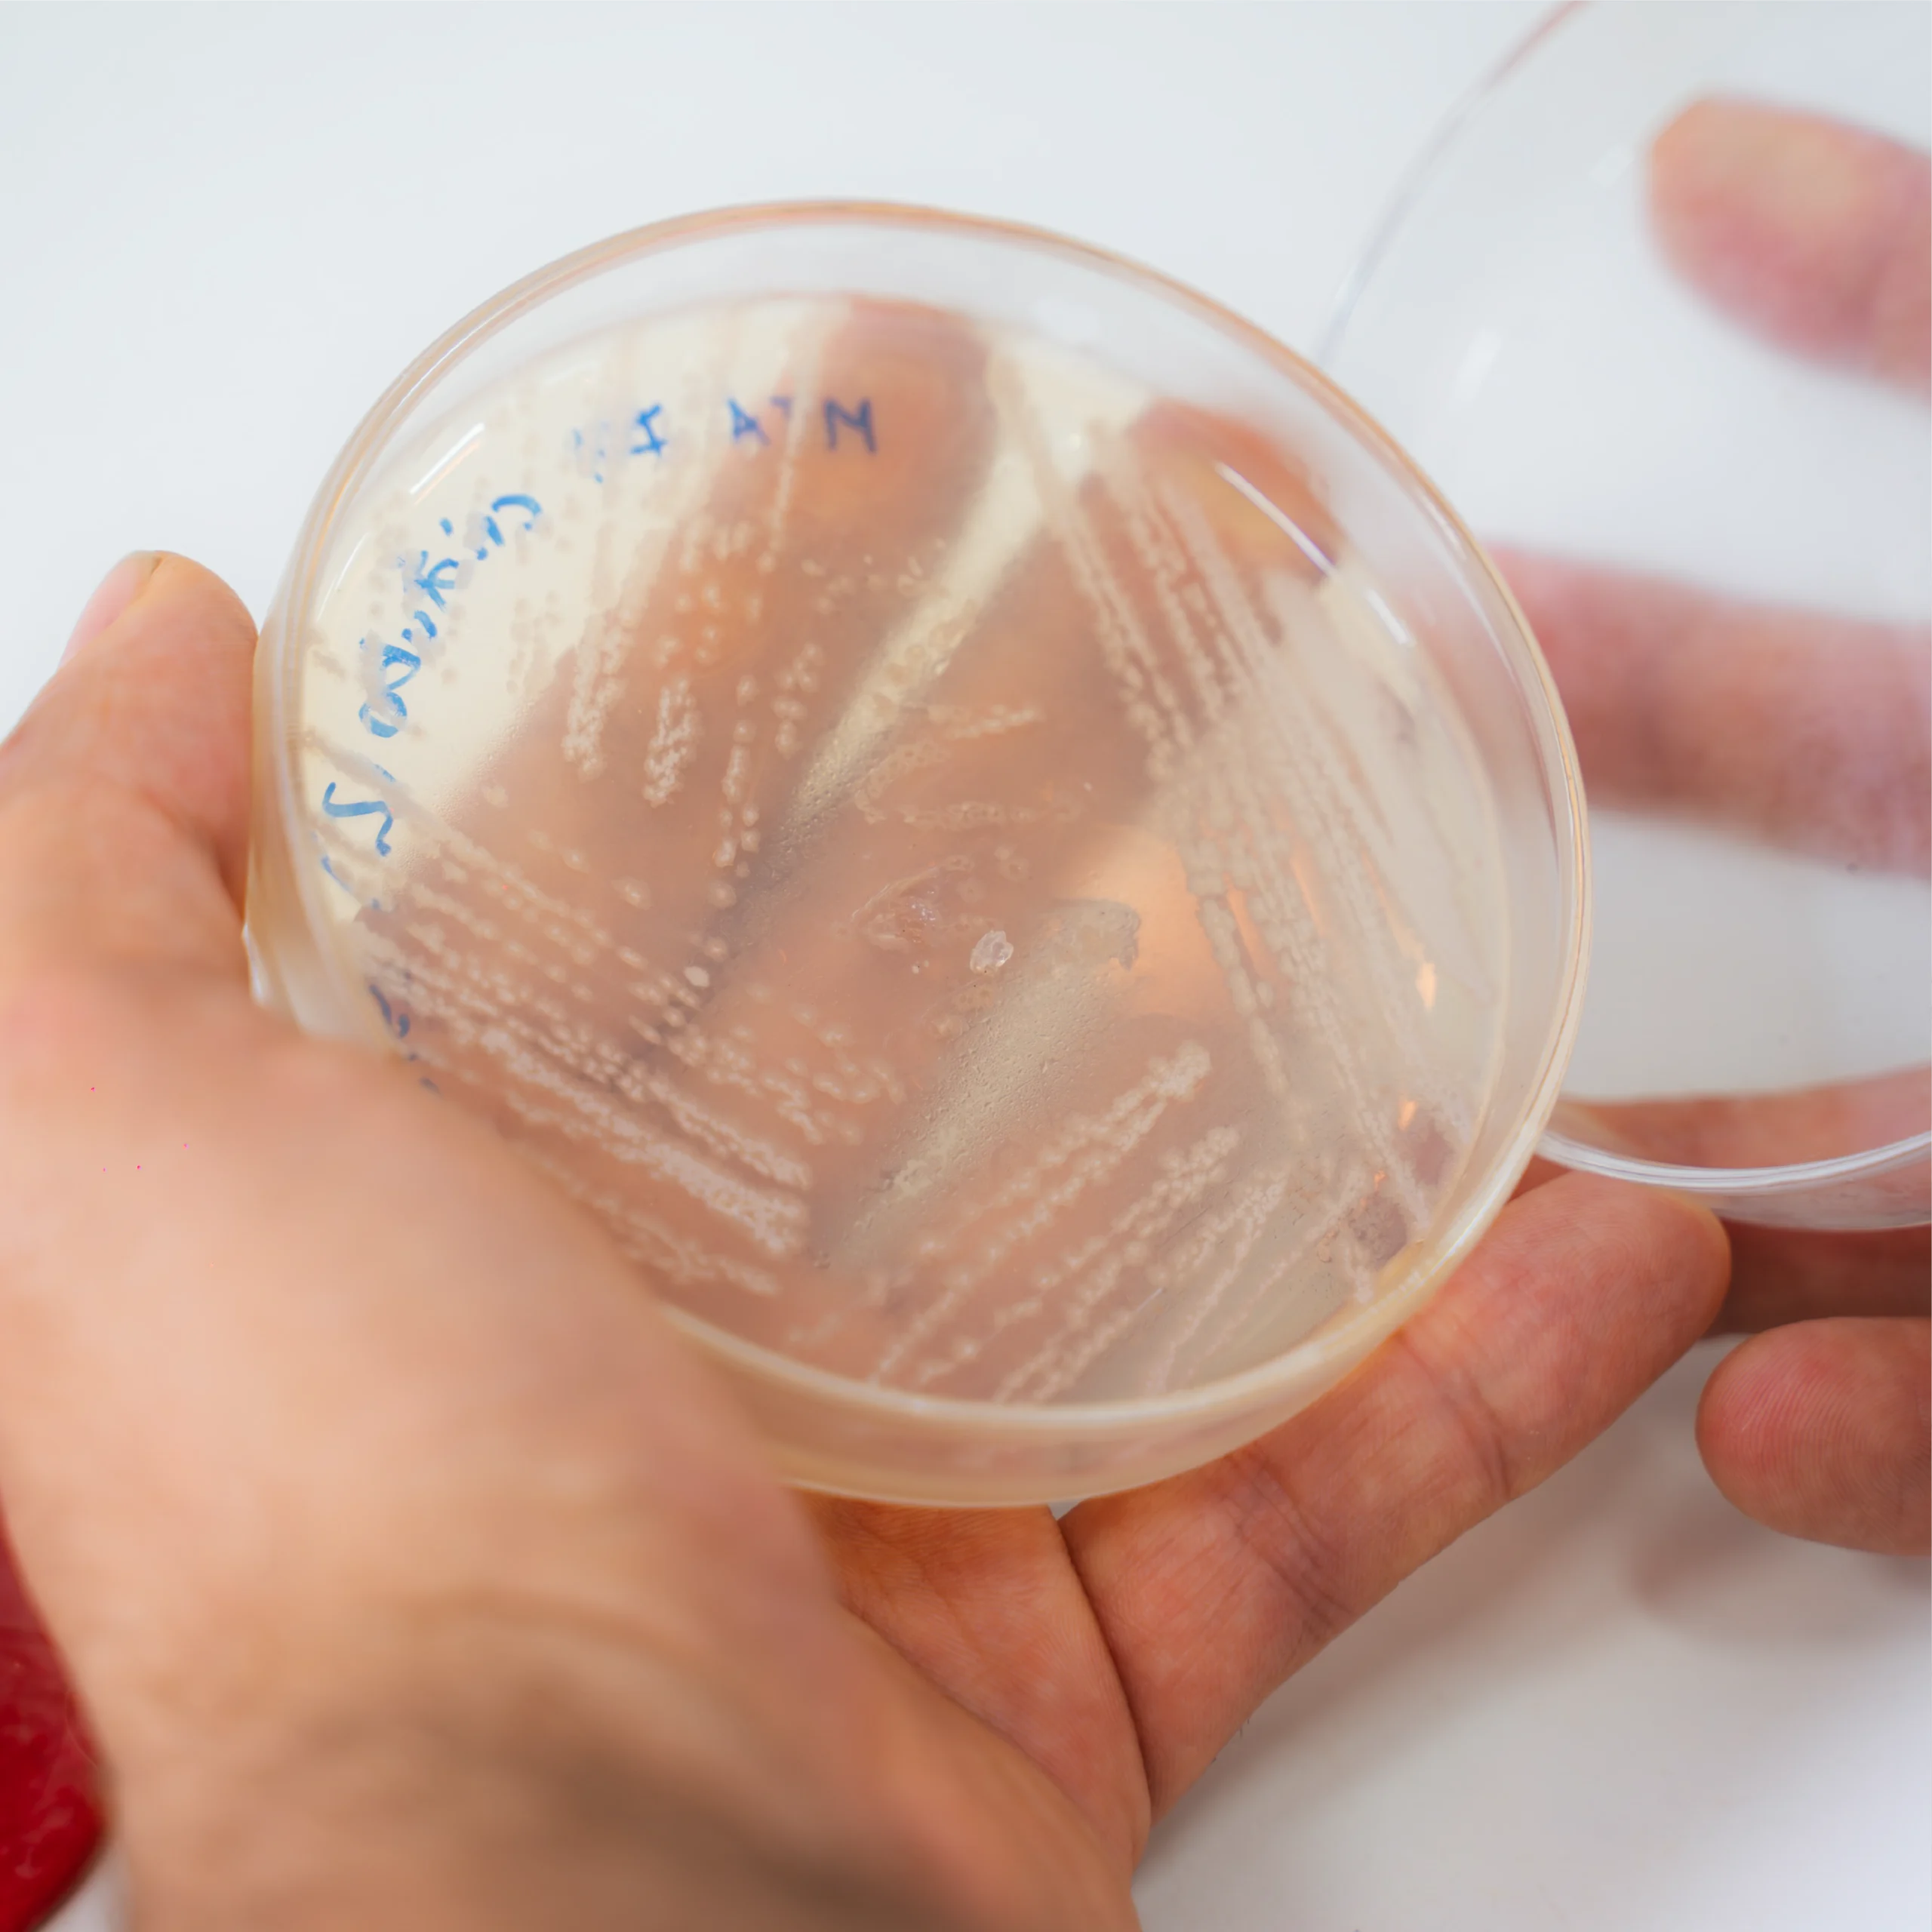

AdiLab es el corazón de Adinnova. Desde nuestro laboratorio, equipado con tecnología de última generación y un banco propio de microorganismos, nacen las investigaciones, innovaciones y desarrollos que definen nuestra propuesta de valor. Ubicado en el Parque Tecnológico Litoral Centro S.A.P.E.M. (PTLC), este espacio impulsa la ciencia aplicada, la formulación de nuevos productos y el respaldo técnico que ofrecemos a nuestros clientes.
Somos Adinnova
En Adinnova desarrollamos aditivos naturales para nutrición animal y rendering, combinando ciencia, innovación y soluciones a medida.
Con base en el litoral argentino, llegamos a cada destino y avanzamos con alianzas estratégicas que expanden nuestra presencia en mercados internacionales.
Nos enfocamos en mejorar los índices productivos y la sanidad animal a través de ingredientes naturales, investigación constante y el trabajo de un equipo interdisciplinario altamente capacitado.
Nuestra gama de productos incluye Colmax, Adimic, Adsor, Hepatosafe, Fibira, FibiraPet, Sinergia, Sinergia Bovinos, Tanfol, TanfolPet, Lipower, Drynova, Envirocron, Natox y Sapnova.
Ofrecemos soluciones para rendering y una amplia variedad de especies: desde avicultura, porcicultura, acuicultura, ganadería y equinos hasta mascotas y animales exóticos.
Somos industria argentina con visión global, comprometidos con el bienestar animal y el cuidado ambiental desde el origen.
La naturaleza es la protagonista de nuestra historia: escuchamos al ecosistema con la certeza de que las combinaciones y el compromiso transforman, construyendo futuro y dejando una huella positiva.
En Adinnova somos innovación, originalidad y versatilidad.
Proactivos por naturaleza.
Nuestras ubicaciones

Planta productiva y logística
Coronda, Santa Fe
Sede administrativa
Coronda, Santa Fe
Desde nuestra sede en Coronda gestionamos el día a día de Adinnova. En este espacio confluyen las áreas estratégicas, comerciales y administrativas que impulsan el crecimiento de la empresa. Es el centro de coordinación y planificación donde se alinean los equipos, se fortalecen los vínculos con nuestros clientes y se consolidan nuestras alianzas.
Oficina comercial
Buenos Aires
Un punto de encuentro estratégico para quienes buscan un espacio confortable donde conversar sobre metas, producción y proyecciones. Nuestro equipo técnico comercial ofrece su experiencia para seguir evolucionando el mundo de la nutrición animal, potenciando combinaciones naturales.

Respeto y cuidado
del medioambiente

Soluciones a medida
de cada cliente

Investigación y
desarrollo

Equipo
especializado

Misión
Nos dedicamos a mejorar la nutrición animal con aditivos naturales y sostenibles, contribuyendo así a un mundo más saludable para todos.

Visión
Buscamos ser líderes en el mercado de aditivos para la nutrición animal, destacándonos por nuestra calidad, cercanía con los clientes y compromiso sólido con la responsabilidad social y el medio ambiente.

Política de Calidad e Inocuidad
En Adinnova nos comprometemos a cumplir con los requisitos de inocuidad y calidad vigentes, para asegurar la elaboración de productos que respondan a los más altos estándares y a las necesidades de nuestros clientes.